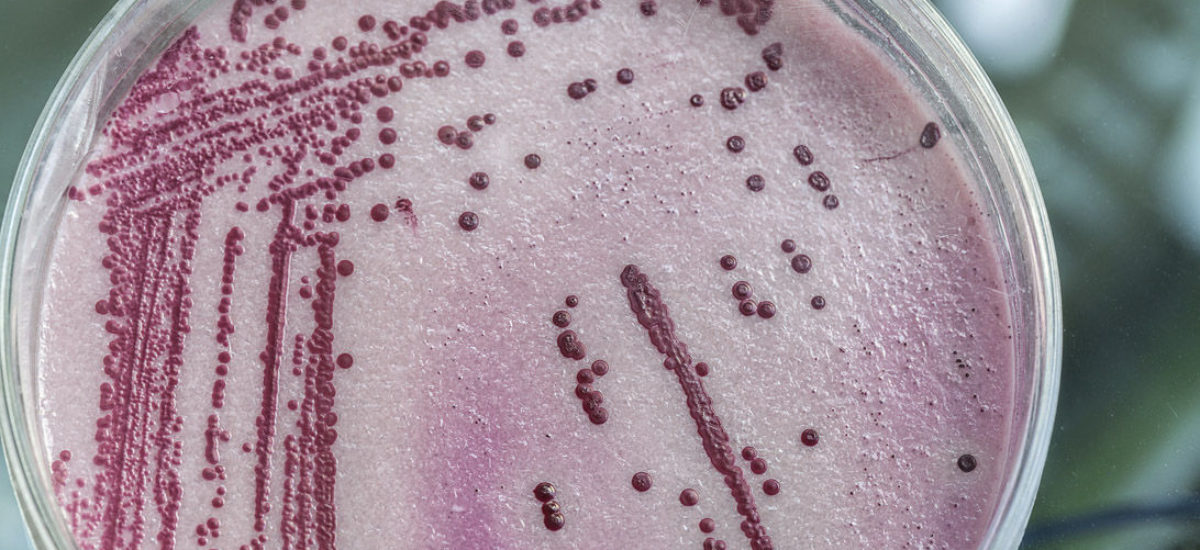

La resistencia antimicrobiana continúa siendo un problema y una amenaza mundial. La capacidad de algunas bacterias a resistir a los tratamientos antibióticos ha puesto en alerta a las autoridades sanitarias de todo el planeta, que trabajan para acabar con la farmacoresistencia. La Organización Mundial de la Salud (OMS) acaba de publicar una lista con “las 12 familias de bacterias más peligrosas para la salud humana”, entre las que se incluyen E. coli, Salmonella o Campylobacter. El artículo explica cuáles son, según la OMS, las 12 bacterias más peligrosas y por qué la resistencia antimicrobiana es un problema creciente.
El mal uso de los antibióticos ha llevado, en los últimos años, a tener que hacer frente a un problema asociado: el de la resistencia de muchas bacterias a sus tratamientos. Esto significa que los microorganismos han dejado de verse afectados por un antimicrobiano al que antes era sensible, como los antibióticos, y, por tanto, las infecciones persisten porque los tratamientos son ineficaces. Este problema se debe, sobre todo, al empleo excesivo y a la mala utilización de los antibióticos.
Para reducirlo, las autoridades sanitarias de todo el mundo llevan años pronunciándose al respecto y apuestan por hacer un uso prudente de los antibióticos, no solo en las personas, sino también en los animales. Lo recomienda ahora la Organización Mundial de la Salud. Según la entidad, en la lucha contra la resistencia antimicrobiana, además de aumentar la investigación, es importante «hacer un empleo apropiado de los antibióticos existentes en la medicina humana y veterinaria, así como un uso racional de cualquier nuevo antibiótico que se desarrolle en el futuro». Además, la OMS ha publicado una lista con la lista de los «patógenos prioritarios» resistentes a los antibióticos, en la que ha incluido las «12 familias de bacterias más peligrosas para la salud humana».
Las 12 bacterias más peligrosas
Los antimicrobianos se utilizan para tratar enfermedades infecciosas en forma de antibióticos a cuyos principios activos los microorganismos presentan cada vez más resistencia. El problema está en que las bacterias han encontrado nuevas formas de resistir a los tratamientos y pueden transmitir material genético que permite a otras bacterias hacerse resistentes. La resistencia afecta a muchos agentes infecciosos distintos, como lo demuestra la lista publicada por la OMS. Entre los patógenos se hallan algunos de transmisión alimentaria. La organización ha dividido la lista en tres categorías:
Prioridad crítica. La OMS incorpora en este apartado las bacterias multirresistentes peligrosas en hospitales, residencias de ancianos y pacientes con dispositivos como ventiladores. Se incluyen Pseudomonas, E. coli, Serratia y Proteus. Estas bacterias han creado resistencia a antibióticos como los carbapenémicos y cefalosporinas de tercera generación.
Prioridad alta. Las bacterias de este apartado provocan intoxicaciones alimentarias. Se encuentran Staphylococcus aureus, Helicobacter pylori, Campylobacter y Salmonella, entre otras. La mayoría son resistentes a las fluoroquinolonas.
Prioridad media. También originan intoxicaciones alimentarias. Se incluyen Streptococcus pneumoniae o Shigella.
La lista de la OMS ha contado con la colaboración de la División de Enfermedades Infecciosas de la Universidad de Tübingen (Alemania). Para su realización, han tenido en consideración factores como el grado de letalidad de los patógenos; la frecuencia con la que presentan resistencia a los antibióticos; la facilidad con la que se transmiten entre animales, de animales a personas y entre personas; si las infecciones pueden prevenirse (con vacunación o higiene); qué alternativas terapéuticas quedan; y si se investigan nuevos antibióticos para tratar las infecciones. El objetivo de este trabajo es, según la OMS, realizar investigaciones que se centren en descubrir nuevos antibióticos.
Resistencia antimicrobiana, un problema creciente
Cuando las bacterias se hacen resistentes a los antibióticos destinados precisamente a acabar con ellas, el tratamiento de las infecciones que causan puede llegar a ser muy difícil e, incluso, imposible. A principios de 2016, la Autoridad Europea de Seguridad Alimentaria (EFSA) y el Centro Europeo para la Prevención y el Control de Enfermedades (ECDC) elaboraron un informe sobre este problema, donde se admitía que la resistencia antimicrobiana continuaba siendo un riesgo para la salud humana y animal. Entonces ya apostaron por dar un enfoque integral que involucre a sectores de la salud pública, la bioseguridad, el medio ambiente o el bienestar animal. El objetivo es minimizar este problema, que aumenta año tras año, y reducir así la capacidad de las bacterias de generar cada vez más resistencia a los agentes antimicrobianos debido a su adaptación al principio activo del fármaco.
Los antimicrobianos son sustancias activas, de origen sintético o natural, capaces de destruir bacterias, reducir su crecimiento o la capacidad de reproducción en animales o seres humanos. En el ámbito de la seguridad alimentaria, el problema plantea la necesidad de identificar cualquier riesgo potencial para los consumidores y establecer medidas de control. Con este fin, en 2006, la legislación europea prohibía el uso de antibióticos en piensos para el crecimiento de ganado. El aumento de la resistencia bacteriana a antimicrobianos lleva años dificultando el tratamiento de algunas infecciones humanas y animales.
Ya entonces se planteó la necesidad inminente de hacer un empleo prudente de los antimicrobianos en animales y la utilización de antibióticos como fluoroquinolones y cefalosporinas solo en casos excepcionales, cuando otros tratamientos no son eficaces. Las bacterias se definen como multirresistentes, si lo son al menos a tres clases de antimicrobianos distintos, según los expertos. En la mayoría de los casos, las cepas de las bacterias zoonóticas más resistentes a antimicrobianos se encuentran en el tracto gastrointestinal de los animales que se destinan a la producción de alimentos.
En las opciones naturales para luchar contra patógenos, han surgido numerosas alternativas antimicrobianas que proceden de especias, hierbas y plantas o sus extractos. El objetivo es que la adición de estos compuestos a los alimentos no afecte ni a las propiedades organolépticas ni a su seguridad. Arándanos, canela, cebolla, orégano o tomillo son algunas de las especias más usadas. Los expertos aseguran que cada una de ellas tiene más de 10 compuestos activos desde el punto de vista biológico.
También se ha estudiado la eficacia de agentes antimicrobianos como ácido láctico y cítrico para mejorar el sabor de alimentos acidificados o fermentados como quesos. En la mayoría de los casos, la acción de los antimicrobianos naturales depende del pH: cuanto más ácido es el alimento, más activo es contra los microorganismos.